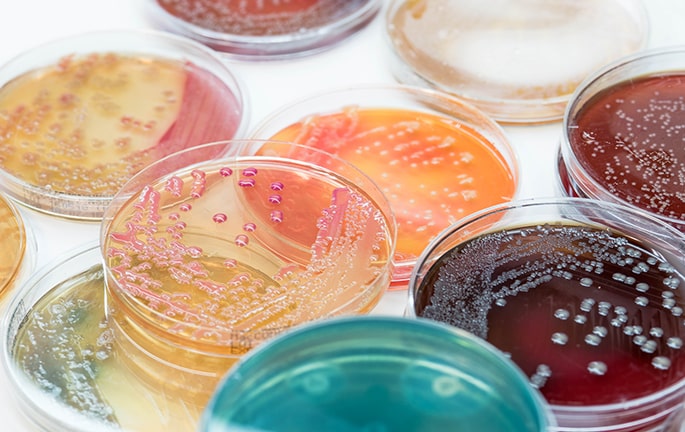
Microbiología y Parasitología

Microbiología y Parasitología
Te contamos todo lo que necesitas saber sobre la microbiología y parasitología: qué estudia, qué trata y cuáles son sus aplicaciones en la medicina. Descubre sus diferentes áreas de trabajo y las principales técnicas que utiliza.
¿Qué es la microbiología y parasitología?
La microbiología y parasitología se dedica al diagnóstico y tratamiento de las enfermedades infecciosas y los patógenos que las provocan. Los últimos avances en esta especialidad se deben a la necesidad de responder ante situaciones que no existían anteriormente. Por ejemplo, la cada vez más acusada resistencia a los antimicrobianos, las infecciones diagnosticadas en enfermos en tratamiento de inmunodepresión o la identificación de nuevos de agentes infecciosos.
Los microbiólogos colaboran con otros especialistas en la educación para el uso adecuado de los antibióticos, algo de vital importancia para evitar la reaparición de enfermedades que se creían erradicadas. Además de centrarse en la investigación en el laboratorio, esta rama de la medicina también tiene carácter asistencial.
¿Qué estudia y qué trata la microbiología y parasitología?
Los progresos en el estudio de la microbiología y parasitología permiten, tanto a la comunidad científica como a la población en general, conocer el origen de las enfermedades, algo que ayuda a prevenirlas y a hacer un seguimiento de su evolución. Una gran parte de los esfuerzos de estos facultativos se centra en la detección precoz, ya que iniciar los tratamientos en una fase temprana de la enfermedad es fundamental en la mayoría de las enfermedades infecciosas.
Para profundizar en su investigación, los especialistas se subespecializan en diferentes ramas. Entre ellas, destacan:
- Micología: enfocada en el estudio de los hongos, los mohos y las levaduras, y en sus efectos perjudiciales en la salud de las personas, ya que cuando estos organismos se alojan en una célula, la degradan para convertirla en sustrato. Esta es la forma en que se producen las infecciones conocidas como micosis, que pueden dividirse en superficiales, cutáneas, subcutáneas o sistémicas, que afectan a órganos internos.
- Virología: centrada en el estudio de los virus, organismos acelulares que necesitan alojarse en otras células para reproducirse, y de las patologías derivadas de su presencia en el organismo. Una de las labores más destacadas de esta rama es el desarrollo de tratamientos específicos y vacunas frente a los virus.
- Bacteriología: orientada a la investigación de las bacterias, células procariotas, y sus efectos en el cuerpo humano. Este tipo de infecciones evolucionan muy rápido porque las bacterias se reproducen a gran velocidad. No obstante, responden fácilmente ante los tratamientos con antibióticos.
- Parasitología. Se centra en el estudio de los gusanos y protozoos que pueden ser responsables de infecciones leves o a veces muy graves, como el paludismo, o cuando afectan a pacientes inmunodeprimidos.
Técnicas, procedimientos y métodos diagnósticos
Los procedimientos en microbiología y parasitología han avanzado mucho en los últimos años gracias a la irrupción de las técnicas moleculares y los equipos de última generación. No obstante, las prácticas más tradicionales continúan siendo uno de los pilares de esta especialidad:
- Microscopía: técnicas utilizadas para observar los microorganismos, que son imposibles de ver para el ojo humano. Para ampliar las muestras, se pueden utilizar fotones de luz (microscopia óptica) o electrones (microscopia electrónica), que ofrecen imágenes con una mejor resolución.
- Cultivos de bacterias: se coloca una muestra de sangre, orina o tejido en un ambiente propicio para la reproducción de los microorganismos. Pasado un tiempo, se observa el cultivo para detectar la presencia o no de bacterias.
- Cultivos micológicos: técnica similar a la anterior que se emplea para detectar infecciones causadas por hongos.
- Técnicas de siembra: se coloca un agente infeccioso en un entorno adecuado para realizar un cultivo y poder observar su evolución. Se puede desarrollar siembra volumétrica, masiva, por inmersión, en doble capa, en superficie o en estría.
- Técnicas de biología molecular: estos novedosos procedimientos permiten detectar las enfermedades más rápidamente y con mayor fiabilidad. La técnica más elemental consiste en la reacción en cadena de la polimerasa (PCR, por sus siglas en inglés), que permite reproducir rápidamente fragmentos de ADN para estudiarlos detalladamente.
- Estudios de sensibilidad antimicrobiana. Se enfrentan las bacterias a diferentes concentraciones de antimicrobianos para determinar cuál de ellos puede ser el más adecuado para el tratamiento de una infección.






























